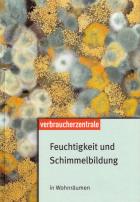

Der Redaktionsservice für die Branchen Bau, Haus- und
Gebäudetechnik, Wohnen, Garten- und Landschaftsbau
Feuchtigkeit und Schimmelbildung in Wohnräumen
| Autor: |
Verbraucherzentrale Bundesverband (Hrsg.) |
| Titel: |
Feuchtigkeit und Schimmelbildung in Wohnräumen
Ratgeber |
| Rezension: |
 Die Probleme mit Schimmelbefall in Wohnräumen nehmen seit Jahren zu. Dabei handelt es sich nicht nur um ein ästhetisches Problem: Schimmelbefall kann auch Gebäude und Gesundheit schädigen. Mit dem jetzt in 14., aktualisierter Auflage erschienenen Ratgeber „Feuchtigkeit und Schimmelbildung in Wohnräumen“ hilft die Verbraucherzentrale beim Erkennen von Ursachen und bei ihrer Beseitigung.
Gerade in neuen Wohnungen treten immer wieder feuchte Stellen und Schimmelbefall auf. Regelmäßig führt das Problem zu Auseinandersetzungen zwischen Mietern und Vermietern über die Schuldfrage. Die kann allerdings erst beantwortet werden, wenn die Ursachen für den Schimmelbefall identifiziert sind. Nicht selten handelt es sich um eine Kombination bauseitiger Mängel und unsachgemäßer Nutzung, die zu „blühenden“ Wänden und Ecken führt.
Der 108-seitige Ratgeber der Verbraucherzentrale erläutert zunächst, warum Feuchteschäden heute häufiger auftreten als früher. Gut verständlich wird erklärt, wieso sich Luftfeuchtigkeit an bestimmten Stellen niederschlägt und Probleme verursacht. Nachdem wirksame Maßnahmen zur Bekämpfung von Schimmelbefall beschrieben sind, widmet sich der Ratgeber abschließend der Schuldfrage zwischen Mieter und Vermieter.
„Feuchtigkeit und Schimmelbildung in Wohnräumen“ kommt inklusive Versandkosten für 8,40 Euro per Post mit Rechnung ins Haus. Bestelladresse:
Versandservice Verbraucherzentrale Baden-Württemberg e.V., Heinrich-Sommer-Straße 13, 59939 Olsberg, Fax 02962 / 80 01 49 oder per Email an: broschueren@vz-bw.de. |
| Infos: |
Verbraucherzentrale Bundesverband, 104 Seiten, ISBN 9783936350029, 8,40 Euro |
| Datum: |
09.06.08 |
| Link: |
Beim Online-Buchhandel bestellen |
 Zur Liste
Zur Liste
Zur Liste
Zur Liste
